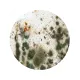

Уничтожим насекомых и грызунов от 890 рублей
- Избавляем от вредителей за 1 час
- Безопасно для людей и животных
- Конфиденциально (переодеваемся на месте)
- Гарантия по договору от 3-х месяцев до 1 года
При заявке с сайта до 30 июня — обработка по ценам прошлого года